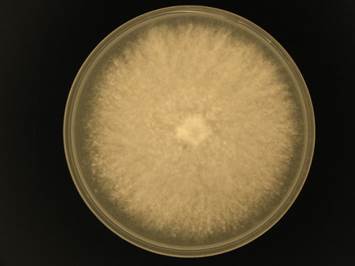

Tyromyces albellus NBRC 31872
| 採取地、分離源など |
Fruit body Otsu, Shiga, Japan |
|---|---|
| Azo-CMC活性 | ++ |
| Azo-avicel活性 | + |
|
菌体外タンパク質 生産性 |
+++ |
| コメント | |
| サブトラクションcDNA情報 | |
| Proteome情報 | |
| Genome配列情報 | |
| 分類情報 | Polyporaceae, Polyporales, Incertae sedis, Agaricomycetes, Agaricomycotina, Basidiomycota |
|
PDA上の コロニーの性状 |
|
| 1D-secretome |

|
この菌株(NBRC株)を入手するには
NBRCでは、このページで紹介しているバイオマス利用関連微生物を提供しております。
菌株の情報は、NBRC Culture カタログ検索:NBRC 31872でもご覧いただけます。
この菌株は「NBRC株」です。
入手方法はこちらをご覧ください。
お問い合わせ
【お問い合わせ先】
〒292-0818
千葉県木更津市かずさ鎌足2-5-8
独立行政法人製品評価技術基盤機構
バイオテクノロジーセンター(NBRC)
開発課(バイオマス担当)
TEL: 0438-20-5763
FAX: 0438-20-5582
E-mail:abs-info@nite.go.jp
お問い合わせ
- 独立行政法人製品評価技術基盤機構 バイオテクノロジーセンター バイオ技術評価・開発課(かずさ) バイオマス担当
-
TEL:0438-20-5764
住所:〒292-0818 千葉県木更津市かずさ鎌足2-5-8 地図
お問い合わせフォームへ








